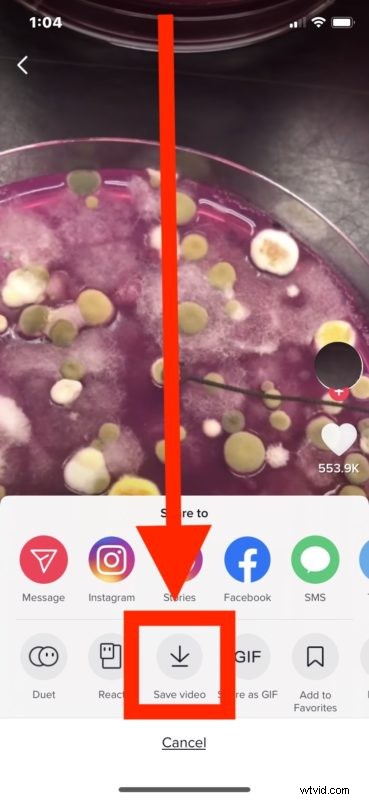
How to Download TikTok Videos to iPhone or iPad: Easy Step-by-Step Guide

Have you ever seen a TikTok video you wanted to download and save to iPhone? Maybe you want to remix and edit the video for your own purposes, or share it with other people, or keep it for offline viewing, or for any other million reasons you may want to save a TikTok video locally to your device.
This article will show you how to download and save videos from TikTok to iPhone or iPad (and for what it’s worth, the process is basically the same for saving TikTok videos on Android too but obviously that’s not the focus here).
How to Download & Save TikTok Videos to iPhone or iPad
- Open TikTok on the iPhone or iPad if you haven’t done so already
- Find the video on TikTok you want to save and download locally to the iPhone or iPad
- Tap on the “Share” button, it looks like an arrow
- Tap on “Save Video” to download the video from TikTok to iPhone
- If you haven’t done so already, you will be prompted to allow TikTok access to the Photos app so that it can download the video file *
- The downloaded TikTok video will appear in the Photos app in the All Photos section and the videos album

That’s about it, now your saved TikTok video is on the iPhone or iPad and ready to watch, share, upload, or do whatever you want with it.
Have fun!
Some of you might be wondering what TikTok even is, let alone why you’d want to download videos from the service. For the less familiar, TikTok is a wildly popular video sharing social app that contains a seemingly infinite number of short video clips covering everything from goofy skits, funny videos, animals, interesting snippets, cute dogs and cats, word salads, pranks, rants, bullying, signaling, stupidity, self-aggrandizement, narcissism parading, and just about anything else you can imagine would appear on a video social network that rates things by popularity. TikTok is incredibly popular with youth around the world, so if you haven’t heard of it or find no particular use for this sort of thing, then you’re probably not the target audience and whether or not you are missing out is a matter of how much you care about that sort of thing. Anyway, this article obviously assumes that you enjoy and use TikTok enough that you want to download videos from the service to your local iPhone or iPad storage, and that’s what you have no learned how to do.
* The prompt to allow TikTok to access Photos is necessary to be able to download videos to the device, as that is where any downloaded videos from the service will be saved to on iPhone or iPad. You can always revoke this access later if you feel like it, though if you’re uploading and downloading TikTok videos often that’s unlikely to be something you’d want to do.

If you know of another approach to saving videos from TikTok to iPhone, iPad, or another device, share it in the comments below.